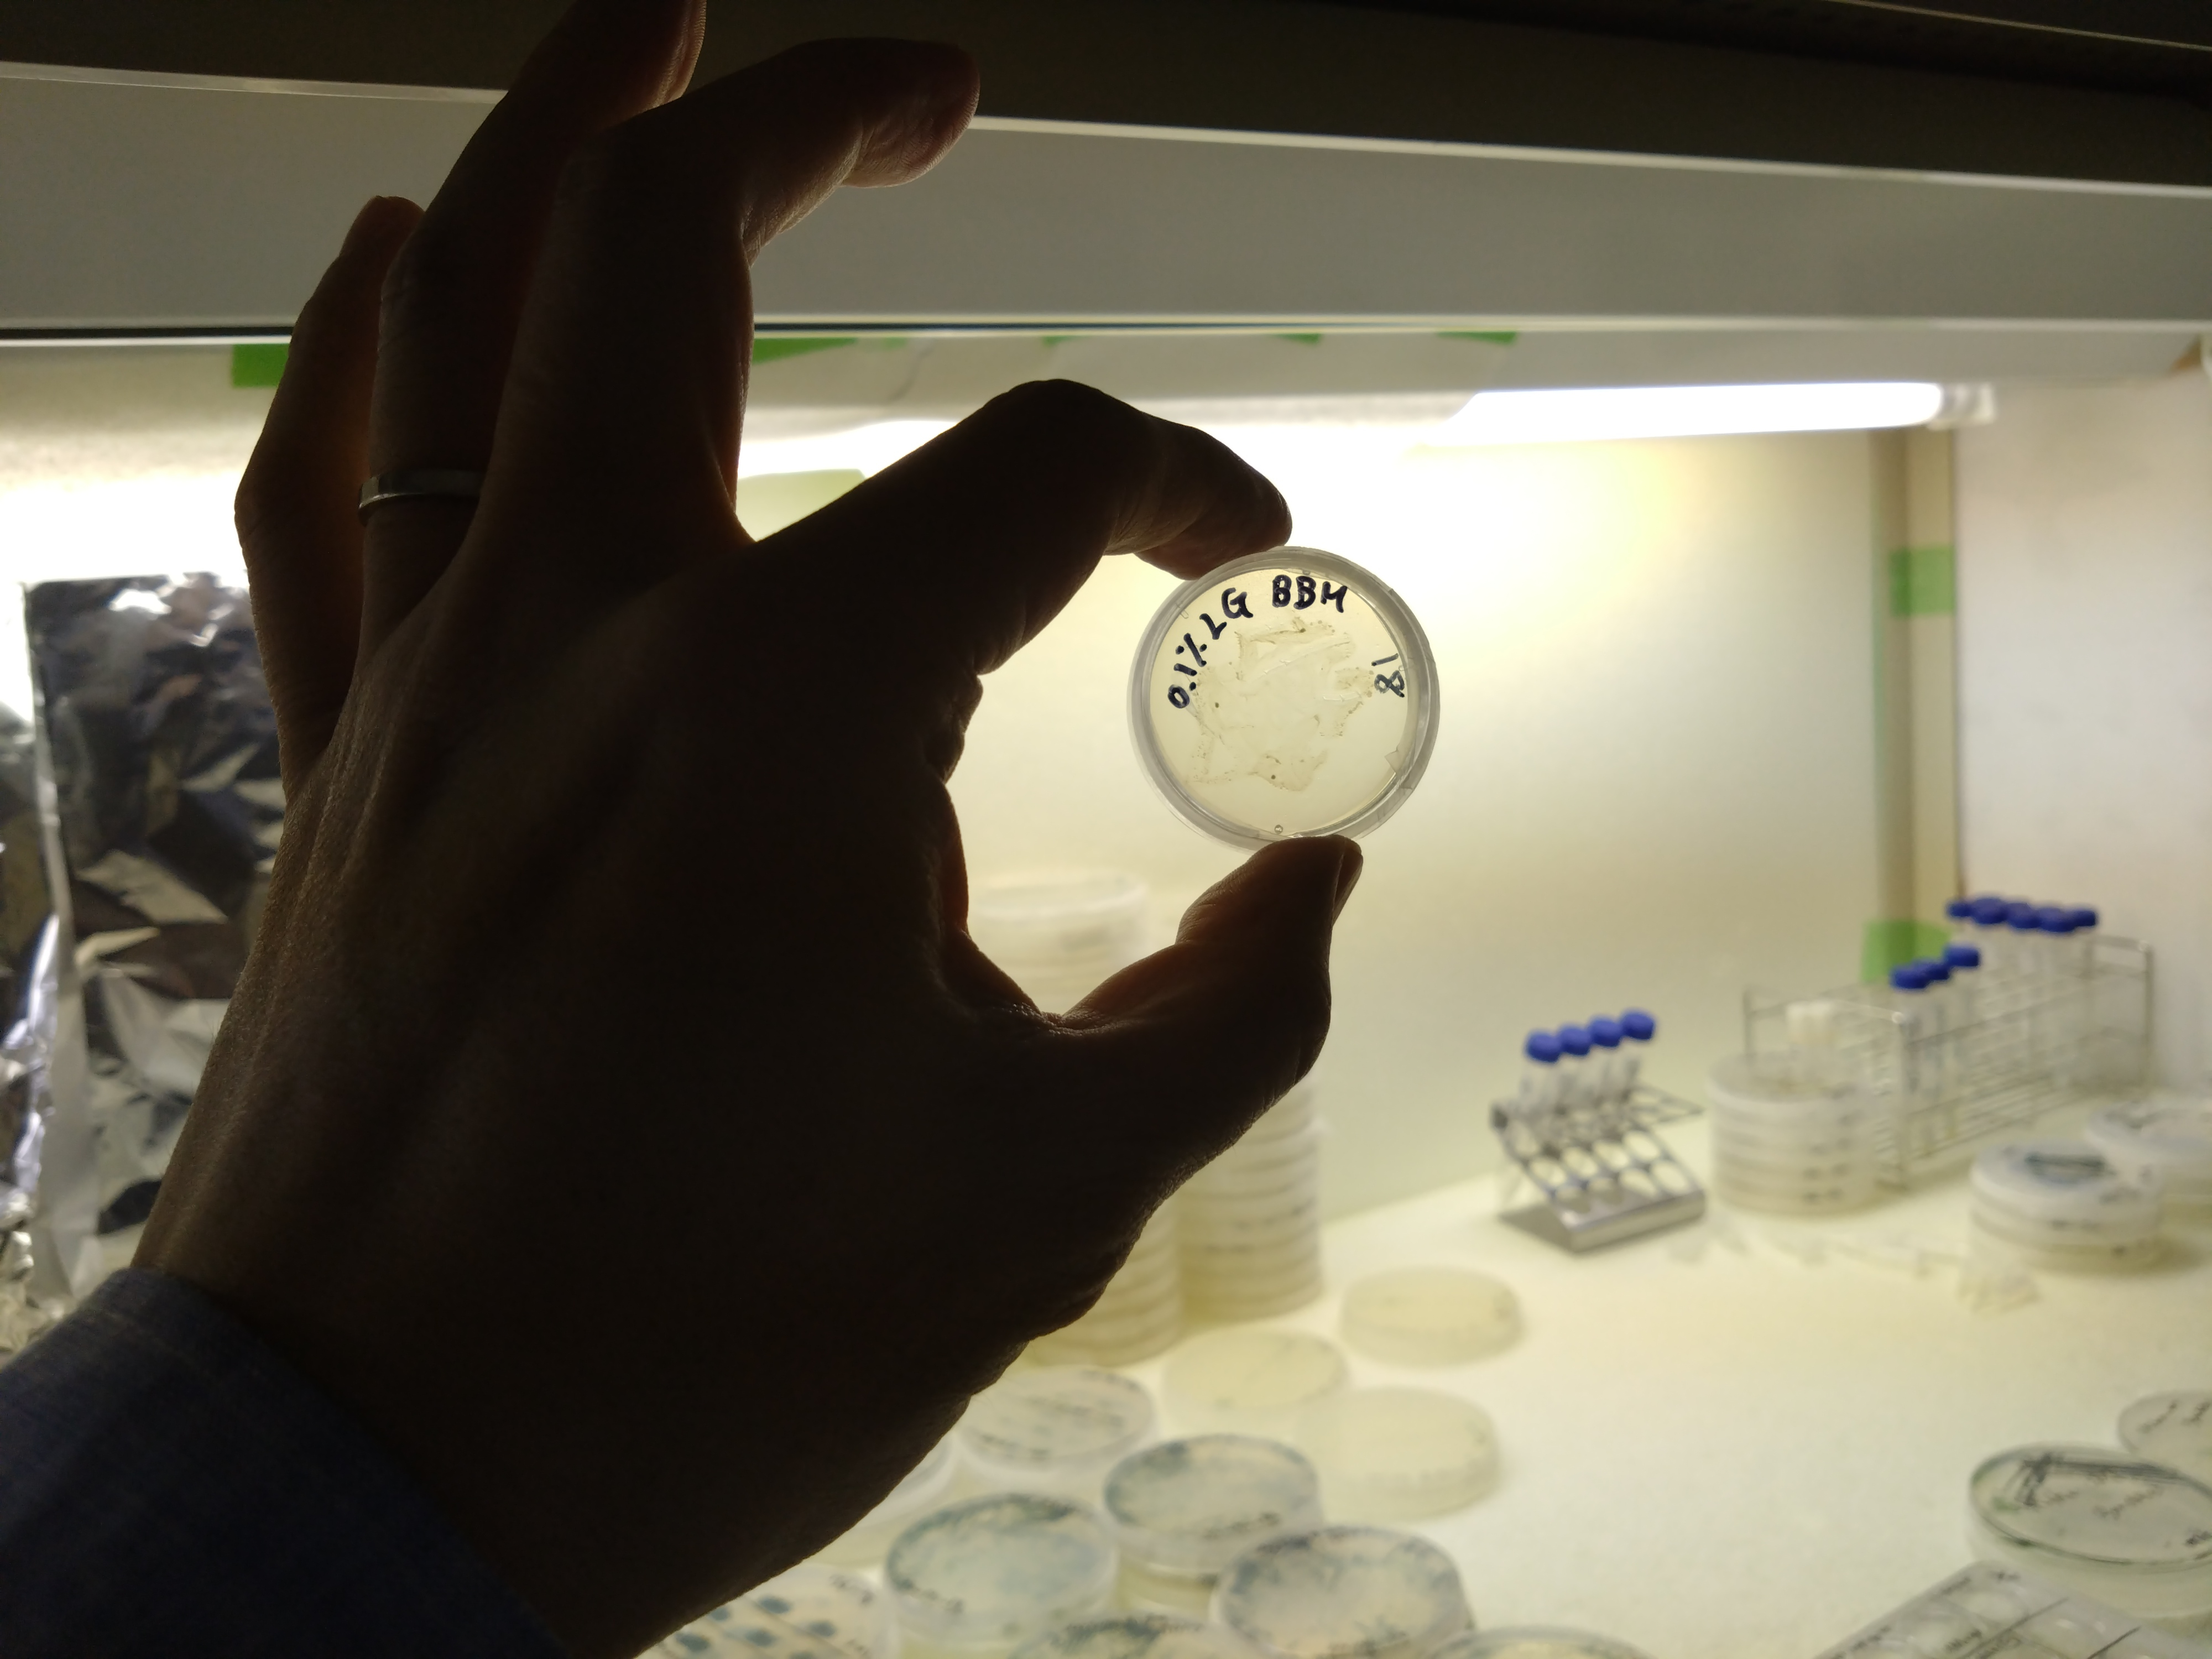
基礎生物学研究所

L-glucose研究会 活動記録
ごあいさつ
L-glucose研究会 代表世話人 石沢 武彰
大阪公立大学 肝胆膵外科
2022年に、共通の知人を介して初めて山田勝也先生とお会いしたときの衝撃は今でも忘れられません。恥を忍んで告白すると、そもそも私は「ふつうのブドウ糖」がD体のみであることを知らない、ダメな外科医でした・・・。そして、天然には存在しないとされているブドウ糖の光学異性体「L-glucose」が一部の腫瘍細胞に取り込まれ、生体内における癌幹細胞的な挙動と関連してそうなこと、この機序を利用した全く新しい制癌治療が成立する可能性に興奮しました。さらに、もしかするとこれは、今の地球上で「ふつうでない」環境に置かれている生物、あるいはL-glucoseが「ふつう」に存在した原始地球の生命体に共通する現象かもしれない――時空を超えた考察に鳥肌が立ったことを覚えています。
この壮大なテーマにチャレンジするために、医学薬学だけでなく、生物学、有機地質学、工学系などの研究者に広くお声掛けし、「L-glucoseが呼び起こす興奮」を共有できる素晴らしいメンバーと今回の研究チームを結成することができました。皆様のご協力に、この場をお借りして厚く御礼申し上げます。今回、満開の桜の下、専門領域を越えた意見交換が行われることで、まだ誰も知らない生命の扉が日本から開かれることを期待しています。世界がL-glucoseという「鍵」に気づく前に。
第1回L-glucose研究会 当番世話人 山田 勝也
弘前大学 大学院医学研究科 分子輸送学講座 特任教授
炭素骨格をもつ地球上生命にとって、糖は最も基本的な炭素源であり、中でもデンプンを構成するなど自然界に多量に存在するD-グルコースは王様とされる。一方、L-グルコースは、ドイツの有機化学者Emil Fischerによる糖の定義以来、D-グルコースの鏡像異性体として生命科学分野では長く陰性対照として使用され、特性も種々報告されてきたが、その生理学的な役割や自然界における存在自体、未知の部分が圧倒的に多い分子である。太陽系の初期の情報を保存すると言われる小惑星Ryuguの地下成分に関し、昨年のScience誌に発表された分析結果は、DLアミノ酸の存在比がほぼ1:1であることを明らかにし、この研究に携わった癸生川陽子先生によるとグルコースについてもD体とL体の比はほぼ1:1であろうと予想されている。であれば、いったいL-グルコースはどこにあるのだろうか?
実はD-グルコースについても、その細胞内への輸送機構や細胞内利用の実態については、不明の部分は少なくない。これは体内で最も多くグルコースを消費する臓器の一つである脳のグルコース利用に関する長年の激しい議論や、放射性フッ素で標識したD-グルコースを多量に取り込むがん患者組織においてグルコーストランスポーターGLUTの発現量が増えていないという報告にも見られるように、生物が体内や体外の環境に併せてどのような様式で細胞内にグルコースを取り込み利用しているのか、不明の部分が少なくない。
こうした状況はグルコースの放射性標識物を使用する方法論だけではなかなか打開されなかったため、一つの方法として蛍光物質による標識、もう一つは関連蛋白の変化を可視化するアプローチがなされ、特に前者は1985年のL. Speizerらによる6-NBDG、1996年の松岡英明東京農工大学教授による2-NBDGの合成以来、四半世紀を超える歴史をもつ。L-グルコースの医療応用の可能性に関する知見は、2-NBDGの陰性対照化合物の必要性から、L-グルコースの蛍光標識物を2007-2008年にかけて開発し、その後、取り込みに関する統計学的な処理を行うために利用した培養がん細胞の解析から、偶然に偶然が重なって2010年に最初に得られた。
筑波大学の中村顕教授はほぼ同時期にL-グルコースそのものを資化(代謝)する土壌菌を発見され、その代謝システムを明らかにし、その後も続々と新しい知見が積み上げられている。中村先生から遅れること10年、コロラド州立大学のClaudia Boot博士らもL-グルコースの資化菌を見出したと述べている。また、最近北海道大学の奥山正幸教授は、インドデカン高原にある現在までよく保存された地球上で唯一の玄武岩上の隕石衝突クレーターに生息する菌からL-グルコシダーゼを発見されその構造を明らかにされた。天然に見いだしにくいL-グルコースは希少糖とも呼ばれ、希少糖は香川大学の何森 健 特任教授らが30年以上にわたり精力的に研究を進めてこられた分野でもあるが、L-グルコースは不思議なことに希少糖研究の中心的テーマとはなってこなかった。
今、L-グルコースの研究は、それぞれの先生方が専門技術と特徴を活かして取り組まれれば新しい知見が次々と得られ、それらが有機的につながれば空間的にも時間的にも広がりのある、あるいは思いもかけないサイエンスに今後発展していく可能性を秘めているものと期待している。第一回研究会は、コロナ下でオンラインミーティングしかできなかった各分野で国内外に名を馳せる忙しい先生方が、桜の季節、実際に一堂に会し、豊富に設定した隙間時間を使って日頃できない個別の突っ込んだお話会いをされる機会をぜひ作りたい、分野の発展に役立てたいという願いを石沢教授と共有して生まれた。
なお、Preliminaryなデータを発表しやすいようにお互い顔のわかった少人数の限定メンバーでclosedの会としたのはこのような意図で、それぞれ科学者としての良心に則って、他の先生方の未発表データには十分なご配慮を。この研究会の試みは、WHOのInternational Agency for Research on Cancer (IARC)、米国NIHのNational Cancer Institute (NCI)、フランスで最も古くからある国立がんセンターの一つCancer Research Centre of Lyon、及び仏大使館からも注目され、支援が得られている。皆様にとってぜひ実りある会となりますよう。
(会議記録)
2024年4月13日 第一回 L-glucose研究会(弘前市)
2024年7月16日 B01 輸送班 会議
2024年8月6日 A01 技術班 会議
2024年8月8日 B02 代謝班 会議
2024年8月8日 C01 医療班 会議
2025年9月12日 探索班会議
2025年9月19日 班長会議
2025年9月20日 医療班会議
(学術集会)
2025年4月26日 第2回 L-glucose研究会開催(当番世話人:石沢 武彰、@大阪公立大学 [Hybrid])
・総勢50名の新進気鋭and/orレジェンドの先生方が集結し、専門領域を超越してL-glucose研究の背景と1年間の進捗を共有しました。
新規に参画された先生からもL-glucose研究への期待が語られ、今後の展開に明確なプランを立案できそうです。
懇親会も大いに盛り上がりました!
プログラム、および発表内容の抜粋(順次更新予定)は下記よりご参照ください。



プログラム: 第2回 Lグルコース研究会プログラム ver.5 (1021.5KB)
基調講演 山田勝也 先生 (13.5MB)
「未知を見る」プロジェクト 活動報告
・2023/11/2 山田G, 石沢G⇒坪井G(東京大学)
・2023/11/14 山田G, 石沢G⇒難波G(徳島大学)
・2023/11/16 山田G, 石沢G⇒池袋G(東京農工大)
・2023/11/20 山田G, 石沢G⇒稲岡G(長崎大学)
・2023/12/7 山田G, 石沢G⇒眞弓・金子G(産総研)
・2023/12/10-12 石沢G(田中涼太 医師)⇒山田G(弘前大学)
・2025/3 石沢G(大学院生 川口貴士)⇒中村G(筑波大学)
・2025/5/21 石沢G⇒小杉G(基礎生物学研究所)
Young Board(幹事: 田中涼太 大阪公立大学)
・2025/6/10 第1回
自己紹介が中心でしたが、ドイツ・ブラジルからの参加者を含め、LG研究に対する期待が述べられる熱いweb会議となりました!

My Archives(動画コンテンツ)
以下のリンクで公開中!
https://cms-admin.omu.ac.jp/med/omu-hbps/info/l-glucose/index.html